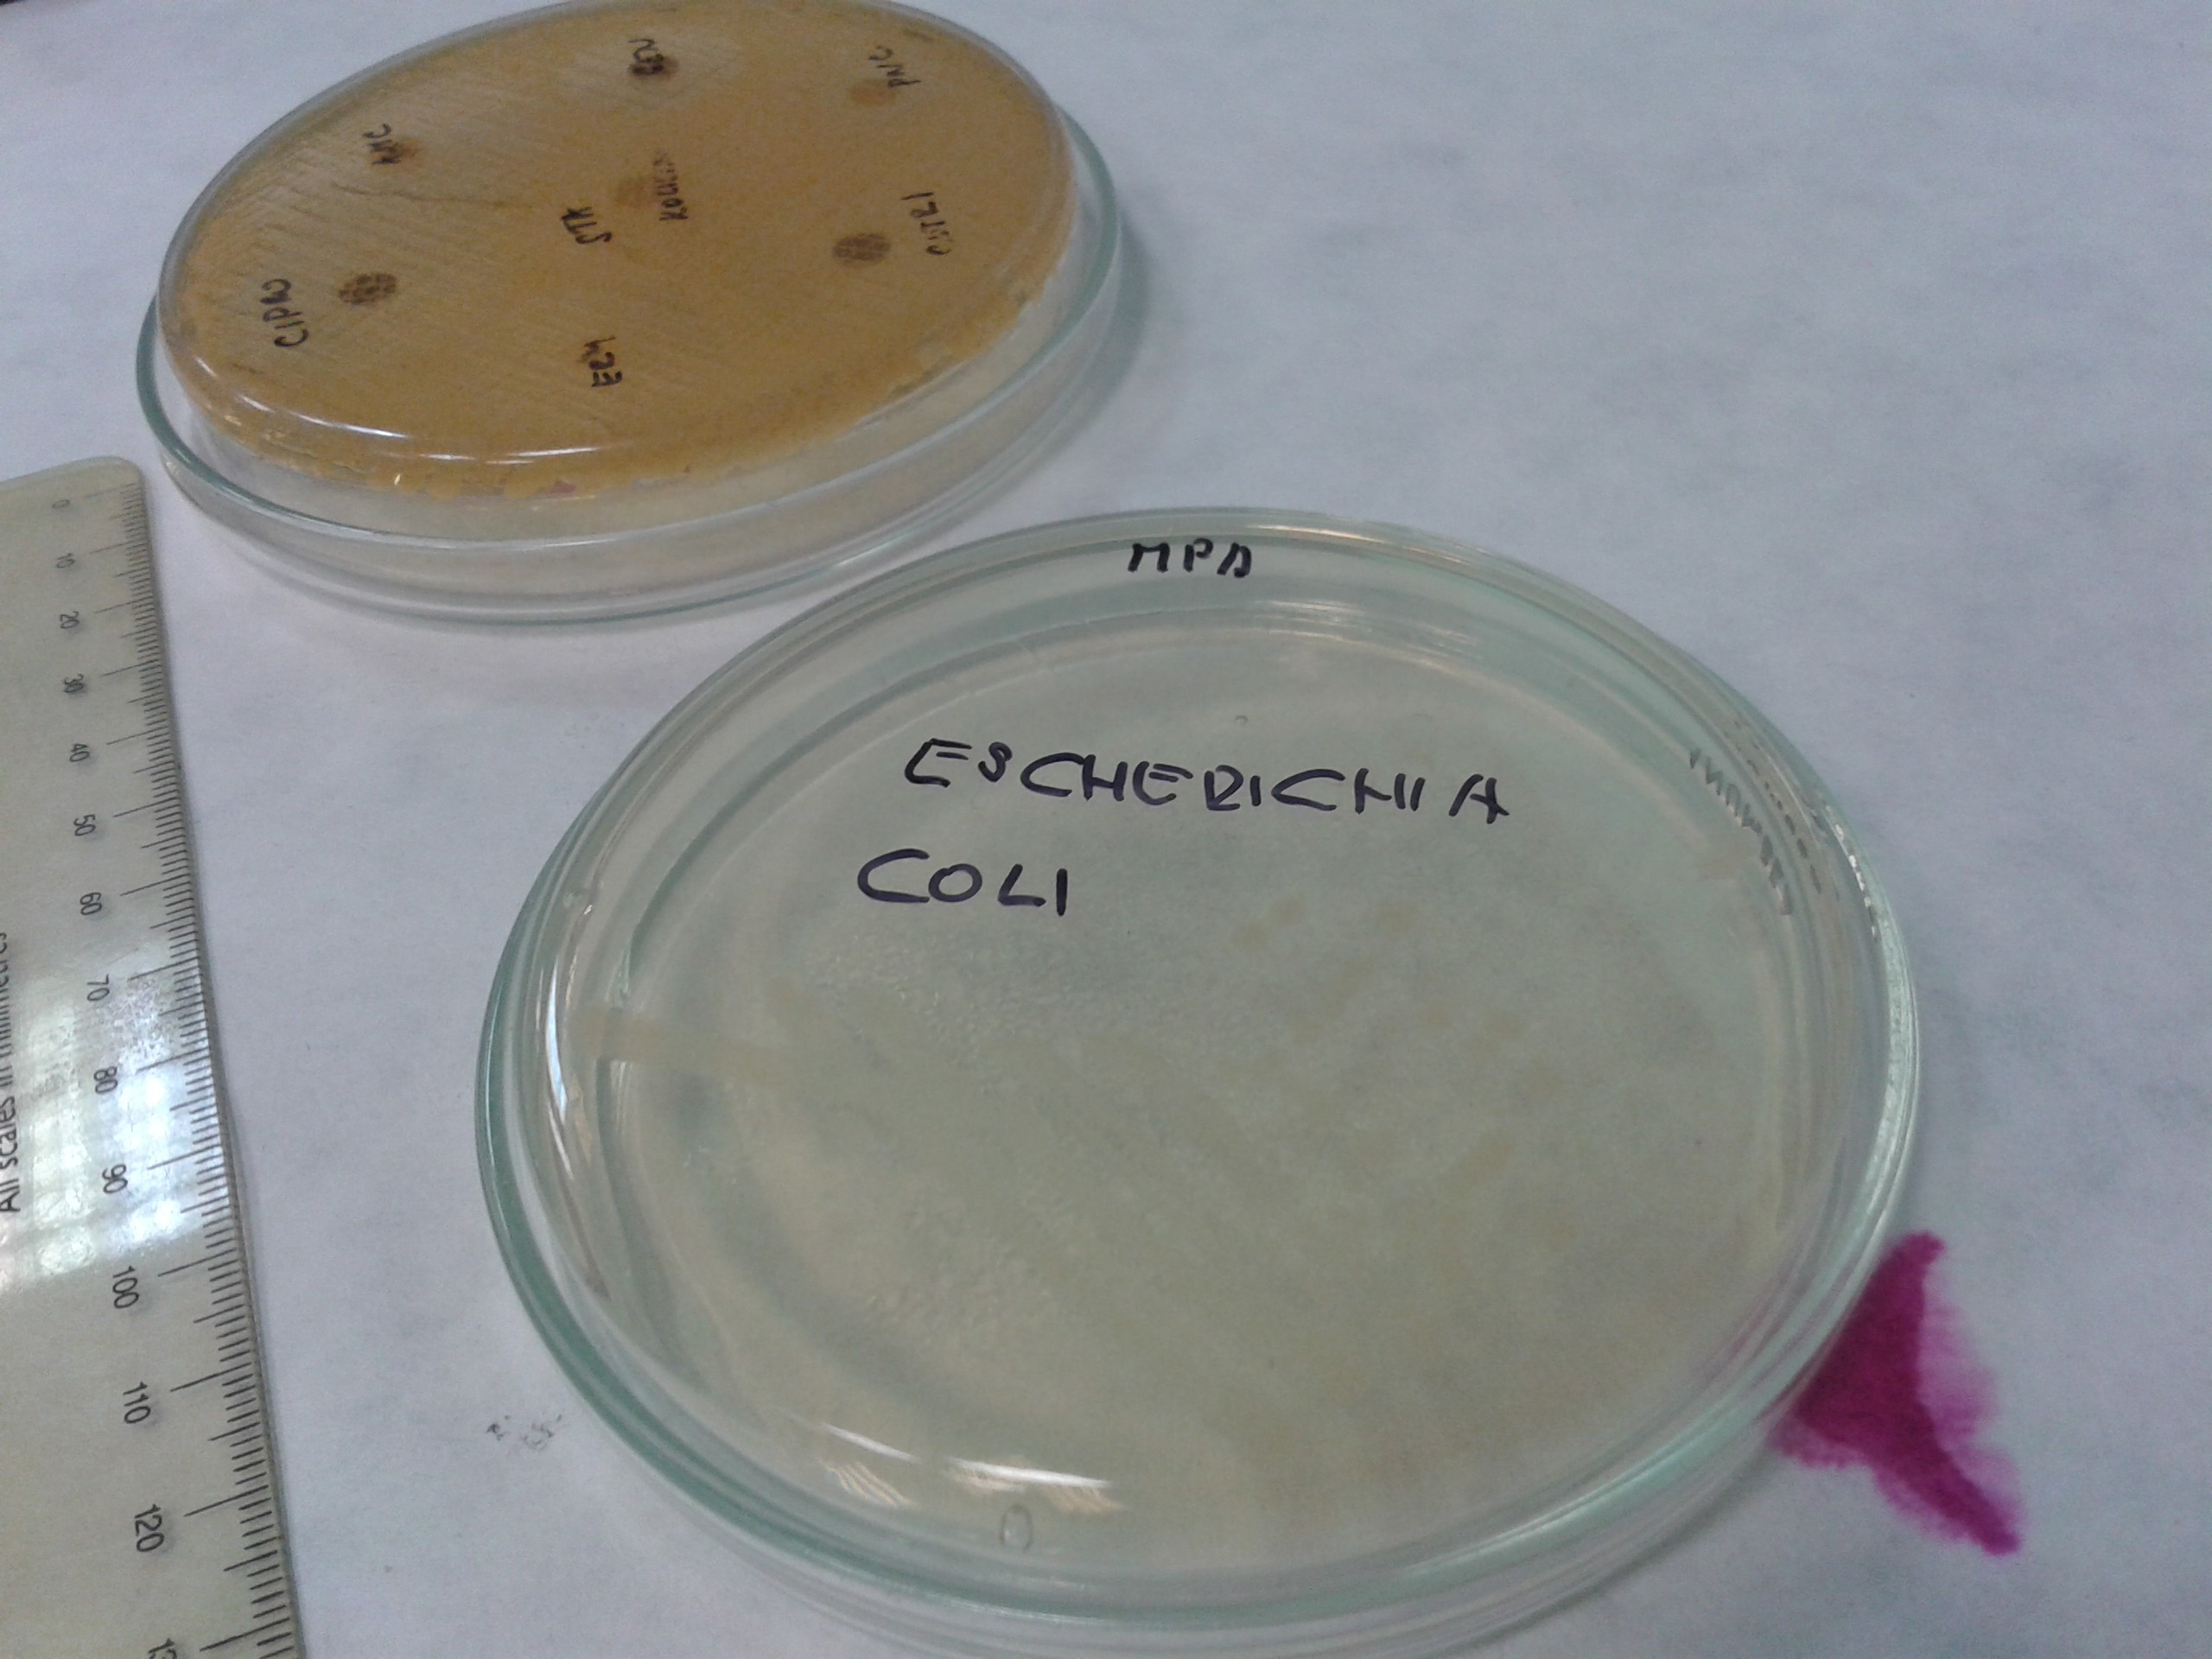

Måndagen började med credit test i histologi. Har dessvärre en känsla av att detta kan vara det första jag misslyckats med under dessa 9 avklarade veckor. Det var ett ganska omfattande prov och jag orkade helt enkelt inte läsa tillräckligt när jag var sjuk. På onsdag får jag veta om jag måste göra om det igen. Håll tummarna att jag slipper det är ni snälla!
I tisdags hade vi immunologi practical där vi fick lära oss principerna för ELISA, dvs. Enzymkopplad immunadsorberande analys, eller Enzyme-Linked ImmunoSorbent Assay på engelska. Detta test används för att kvantifiera och detektera en antikropp eller ett antigen och kan upptäcka olika allvarliga sjukdomar som till exempel HIV eller borrelia. Rätt spännande faktiskt 🙂



Kvällen ägnades åt att försöka lösa en klurig genetikuppgift = karyotypering. Vi hade fått varsin papperskopia av en uppförstorad bild på kromosomer i mikroskop. Uppgiften gick ut på att klippa ut dem, sortera dem i par efter sort och storlek och sedan fastställa vilken art och könstillhörighet djuret hade. Inte så lätt som man först kunde tro och speciellt inte med min hjärna som snabbt gör sina egna associationer till allt. Lägger upp en bild så fattar ni kanske hur jag menar…

I onsdags köpte jag äntligen nya joggingskor och två par jeans. Det var verkligen dags! Satte också upp lite fler tavlor för att försöka få mer hemkänsla i Skokartongen. Har nyligen haft ett återfall med en otroligt stark längtan efter att bo i hus igen och inte blev det bättre när jag hittade den här annonsen:
http://reality.bazos.sk/inzerat/43336059/Rodinny-dom-prenajom-Kosice-Sever.php
Det huset hade varit helt perfekt. Nära skolan, inhägnad tomt till hundarna, stor terass, öppenspis, badkar, garage med mera. Tyvärr har jag inte råd att flytta dit själv och känner ingen här som vill dela det med mig. Lockas inte riktigt av tanken att dela bostad med någon helt okänd heller så tills vidare får jag nog bli kvar i min lilla Skokartong. Gudskelov har det äntligen blivit lite svalare här så fram tills våren fungerar det ju i alla fall.


Tre stycken som betytt/betyder mycket i mitt liv: från vänster Lazzo (R.I.P), Pixie och gamla Solero (R.I.P)

Äntligen verkar det hända något. Mycket tack vare Runkeeper & Lifesum som ger lite bättre koll på läget. Denna vecka har jag avverkat sammanlagt drygt 15 km till fots och mer ska det hinna bli.

Nu…

Vägen mot målet!

Då = målet.
Torsdagen var en underbar dag! Ännu ett anatomi credit test avklarat utan problem. Eftermiddagens fysiologi practical bjöd på en trevlig överraskning – vi skulle gå till stallarna och träna på att ta puls samt lyssna på hjärtfrekvens. ”Patienterna” var denna gången får och getter. Älskar de sistnämnda! Så otroligt söta och charmerande små varelser. (Speciellt dessa utan horn som annars kan vara kännbara). På fredagen var vi på studiebesök till ett mejeri och inspekterade produktionen.


Trivs alldeles utmärkt med stetoskop runt halsen. Om någon känner för att donera ett av bra kvalitet så skulle jag gärna vilja ha ett eget. Gärna ett dissektionskit med många skalpellblad, pincett och sax också 😉
På torsdagskvällen fick jag efterlängtat besök från Sverige av min kära barndomsvän Ulrica som jag inte hunnit träffa sedan förra julen. Det bästa med riktiga vänner är att det inte spelar någon roll hur lång tid det går mellan gångerna man ses. Man fortsätter bara umgås på samma sätt som man i princip alltid har gjort. Okej, visst blir det kanske lite annorlunda när vännerna skaffar familj. Lite mer vuxet och sansat nu än det var förr i tiden, men ändå alltid lika trevligt och alltid lika mycket att prata om. Vi har haft en mycket mysig helg med lite sightseeing, shopping och trevliga restaurangbesök.
Här är några blandade bilder:







Indiskt och öl på Passage 2 India

Har konstigt nog inte ätit sushi sedan jag kom hit. Nu var det dags. Som jag längtat!

Mycket trevlig restaurang som jag lätt kommer att besöka fler gånger.

I Slovakien är det vanligt att lägga till -ova’ till alla kvinnliga efternamn. Även de utländska. Kunde ändå inte låta bli att fnissa när vi såg en bok av Selma Lagerlöfova’ som en del i den mysiga inredningen.

Första köttbiten på flera månader blev en medium-rare hjortfilé ackompanjerad av rostad potatis, en fantastisk sås samt ett glas av det godaste rödvin jag druckit på länge. Slovakien levererar!
I natt åkte gästerna hem så nu är jag ensam igen. Skönt med tystnaden den första kvarten vid morgonkaffet i morse, sedan blev det tomt och lite småtråkigt. Ingen sol ute idag heller.

Lyckan när man fått flera paket med RIKTIGT svenskt kaffe. Dessutom också en hel del matvaror så nu kanske jag kan komma igång och laga lite mat igen. Gillar ju det egentligen, det är bara så tråkigt att göra det till enbart sig själv. Lägenheten är såpass liten att man inte riktigt får plats med middagsgäster heller. Som köksbord har jag numera min lilla cafémöbel som jag hade i glasverandan på Skattegården. Hade egentligen tänkt ha bord + två stolar på balkongen här men det fick inte plats. I helgen lyckades vi i alla fall göra om den här lilla 1:an till en 2:a, så det gick bättre än förväntat att bo 3 personer här. Madrass i köket blev en bra nödlösning åt mig. Kändes nästan som när man åkte på läger/skolresor i sin ungdom 🙂

Stolar och filt fick bli till en liten avskärmning mellan rummen. Madrass till höger i bild.

Har också fått bilder på lilla Pixie som växer och frodas, snart 1,5 år gammal. Längtar verkligen efter att få träffa henne till jul! Hästabstinensen är så jobbig att jag inte ens klarat av att gå och klappa på hästarna som är på skolan ännu. Försöker förtränga mitt gamla liv in i det längsta. Låta bli att tänka på att jag tvingades sälja min fina Mahrous och att han inte kommer finnas kvar i stallet när jag kommer hem igen.
Men, så här är det:



Ett tydligt tecken på att man inte jobbat eller ens träffat hästar på alldeles för lång tid måste vara när ens naturliga naglar plötsligt ser ut så här!! Men lite glamour i mitt liv har jag fasen förtjänat, hihi 😀
Dags att hoppa ur mysbrallorna och göra något vettigt av den här dagen kanske? Det är tydligen någon helgdag här imorgon så vi är lediga då med. Passar bra, för jag har en del att plugga ikapp efter mina sjukdagar förra veckan.
Ha en bra vecka!

![20150130_114300[1]](https://livetblog.com/wp-content/uploads/2015/02/20150130_1143001.jpg?w=300&h=225)
![20150130_111100[1]](https://livetblog.com/wp-content/uploads/2015/02/20150130_1111001.jpg?w=300&h=225)

![20150130_120056[1]](https://livetblog.com/wp-content/uploads/2015/02/20150130_1200561.jpg?w=300&h=225)

![20150130_120050[1]](https://livetblog.com/wp-content/uploads/2015/02/20150130_1200501.jpg?w=300&h=225)
![20150201_163219[1]](https://livetblog.com/wp-content/uploads/2015/02/20150201_1632191.jpg?w=335&h=251)
![20150201_230608[1]](https://livetblog.com/wp-content/uploads/2015/02/20150201_2306081.jpg?w=225&h=300)
![20150203_195753-1[1]](https://livetblog.com/wp-content/uploads/2015/02/20150203_195753-11.jpg?w=640&h=274)


![IMG_23047387871369[1]](https://livetblog.com/wp-content/uploads/2015/01/img_230473878713691.jpeg?w=370&h=208)
![IMG_341475655169688[1]](https://livetblog.com/wp-content/uploads/2015/01/img_3414756551696881.jpeg?w=201&h=357)
![IMG_416311387957042[1]](https://livetblog.com/wp-content/uploads/2015/01/img_4163113879570421.jpeg?w=300&h=225)

![20141227_114645[1]](https://livetblog.com/wp-content/uploads/2015/01/20141227_1146451.jpg?w=258&h=194)

![20141231_221849[1]](https://livetblog.com/wp-content/uploads/2015/01/20141231_2218491.jpg?w=300&h=225)

![20141231_093500[1]](https://livetblog.com/wp-content/uploads/2015/01/20141231_0935001.jpg?w=225&h=300)
![20150112_154259[1]](https://livetblog.com/wp-content/uploads/2015/01/20150112_1542591.jpg?w=225&h=300)
![20150112_154311[1]](https://livetblog.com/wp-content/uploads/2015/01/20150112_1543111.jpg?w=225&h=300)
![20150112_110031[1]](https://livetblog.com/wp-content/uploads/2015/01/20150112_1100311.jpg?w=365&h=274)
![20150112_101631[1]](https://livetblog.com/wp-content/uploads/2015/01/20150112_1016311.jpg?w=640&h=480)
![20150121_155916[1]](https://livetblog.com/wp-content/uploads/2015/01/20150121_1559161.jpg?w=280&h=210)

![IMG_41044599825509[1]](https://livetblog.com/wp-content/uploads/2015/01/img_410445998255091.jpeg?w=300&h=300)













































































![20141031_204022[1]](https://livetblog.com/wp-content/uploads/2014/11/20141031_2040221.jpg?w=412&h=309)
![20141101_161958[1]](https://livetblog.com/wp-content/uploads/2014/11/20141101_1619581.jpg?w=342&h=456)